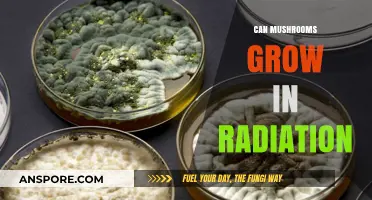
Mushrooms and Radiation: Unveiling Their Survival in Extreme Environments

The idea of mushrooms growing in the human intestines is a topic that sparks curiosity and often stems from misconceptions about fungi and the human digestive system. While mushrooms are fungi that typically thrive in environments rich in organic matter, moisture, and oxygen, the human intestines present a vastly different ecosystem. The intestines are a complex, dynamic environment characterized by a lack of oxygen, high acidity in the stomach, and the presence of digestive enzymes and a diverse microbiome. These conditions are not conducive to the growth of mushrooms, which require specific substrates, oxygen, and stable environmental conditions to develop. Additionally, the human immune system and gut flora actively work to prevent the colonization of foreign organisms, making it highly unlikely for mushrooms to establish themselves in the intestines. Thus, while the concept may seem intriguing, scientific understanding confirms that mushrooms cannot grow in the human intestines.
Explore related products
What You'll Learn
- Conditions for Intestinal Growth: Do mushrooms require specific conditions to grow inside the human intestines
- Types of Mushrooms: Which mushroom species could potentially grow in the intestinal environment
- Health Implications: What are the health risks if mushrooms grow in the intestines
- Prevention Methods: How can one prevent mushrooms from growing in the intestines
- Scientific Evidence: Is there any documented evidence of mushrooms growing in human intestines

Conditions for Intestinal Growth: Do mushrooms require specific conditions to grow inside the human intestines?
Mushrooms thrive in environments rich in organic matter, moisture, and specific temperature ranges, typically between 55°F and 60°F (13°C and 16°C). The human intestines, however, present a vastly different landscape. With a temperature of around 98.6°F (37°C) and a highly acidic to slightly alkaline pH (1.5–7.0), the gastrointestinal tract is far warmer and more variable in acidity than ideal mushroom-growing conditions. Additionally, the intestines are constantly in motion, with peristalsis (muscular contractions) moving contents along, which disrupts the stability needed for fungal growth. These fundamental discrepancies immediately cast doubt on the possibility of mushrooms establishing themselves in this environment.
Consider the mycelium, the vegetative part of a fungus that grows and spreads to form mushrooms. Mycelium requires a substrate—a nutrient-rich base like wood, soil, or compost—to anchor and feed on. The intestinal lining, composed of a single layer of epithelial cells, lacks the structural complexity and nutrient density of such substrates. While the intestines contain undigested food particles, they are in constant flux, offering no stable surface for mycelium to colonize. Even if spores were to enter the intestines, they would likely be expelled before germinating, as the transit time for food through the digestive system averages 24–72 hours, far shorter than the days to weeks required for mycelium to establish itself.
From a microbial competition perspective, the intestines are already home to trillions of bacteria, viruses, and other microorganisms that form the gut microbiome. This ecosystem is highly competitive, with existing microbes rapidly consuming available nutrients and producing antimicrobial compounds to protect their territory. For mushrooms to grow, they would need to outcompete these established residents, a feat unlikely given the specialized adaptations of gut bacteria. For instance, *Lactobacillus* species produce lactic acid, creating an acidic environment hostile to most fungi. Without a mechanism to counteract these defenses, mushrooms would struggle to survive, let alone proliferate.
Practical scenarios where mushrooms might interact with the intestines, such as ingestion of undercooked or raw mushrooms, do not result in internal growth. Instead, the digestive system breaks down fungal cell walls, releasing nutrients for absorption. Even in cases of fungal infections like candidiasis, the organisms involved (e.g., *Candida albicans*) are yeasts, not mushrooms, and their growth is typically limited to mucosal surfaces rather than the intestinal lumen. To prevent accidental fungal exposure, ensure mushrooms are thoroughly cooked to denature proteins and eliminate potential pathogens. For individuals with compromised immune systems, consult a healthcare provider for specific dietary guidelines, as even trace amounts of fungi could pose risks.
In conclusion, the human intestines lack the necessary conditions for mushrooms to grow. From incompatible temperature and pH levels to the absence of a stable substrate and fierce microbial competition, the gastrointestinal tract is an inhospitable environment for fungal development. While mushrooms are a fascinating and diverse kingdom of organisms, their growth remains confined to external ecosystems, leaving the intestines firmly in the domain of bacteria and other specialized microbes.
Can Mushrooms Thrive in Partially Colonized Jars? Key Insights
You may want to see also

Types of Mushrooms: Which mushroom species could potentially grow in the intestinal environment?
The human gut is a complex ecosystem, teeming with microorganisms that play crucial roles in digestion, immunity, and overall health. While mushrooms are typically associated with soil and decaying matter, the question arises: could certain mushroom species thrive in the intestinal environment? To explore this, we must consider the unique conditions of the gut—warm, moist, and rich in organic matter—and identify fungi that might adapt to such an environment.
Analytically speaking, the intestinal tract presents challenges for fungal growth, including competition with bacteria, fluctuating pH levels, and the immune system’s defenses. However, some mushroom species are known for their resilience and ability to colonize harsh environments. For instance, *Candida albicans*, a yeast-like fungus, is a common inhabitant of the human gut, though it is not a mushroom in the traditional sense. True mushrooms, such as those in the Basidiomycota division, typically require oxygen and specific substrates to grow, which the anaerobic conditions of the intestines lack. Yet, species like *Ganoderma lucidum* (Reishi) and *Trametes versicolor* (Turkey Tail) have been studied for their ability to survive in diverse environments, raising questions about their potential to adapt to the gut.
From an instructive perspective, if one were to hypothesize about mushrooms growing in the intestines, the focus should be on species with mycelial networks capable of breaking down complex organic matter. *Pleurotus ostreatus* (Oyster Mushroom) is a prime example, as it thrives on lignin and cellulose, substances found in plant-based gut contents. However, introducing such mushrooms intentionally would require careful consideration of dosage—micro-dosing mycelium extracts (e.g., 0.5–1 gram daily) might be safer than whole fruiting bodies, which could disrupt gut balance. For age categories, adults with healthy immune systems are better candidates for experimentation, while children and immunocompromised individuals should avoid such practices.
Persuasively, the idea of mushrooms growing in the intestines remains largely theoretical, with no scientific evidence confirming their natural colonization. However, the gut microbiome’s plasticity suggests that under specific conditions—such as prolonged exposure to fungal spores or altered gut flora—certain species might temporarily establish a presence. For instance, *Coprinus comatus* (Shaggy Mane) is known for its saprotrophic nature and could, in theory, exploit necrotic tissue in inflamed intestines. Yet, this scenario is highly speculative and underscores the need for rigorous research before drawing conclusions.
Comparatively, while mushrooms like *Agaricus bisporus* (Button Mushroom) are unlikely to grow in the gut due to their oxygen requirements, species like *Aspergillus* and *Penicillium* (though not mushrooms) demonstrate fungi’s adaptability to internal environments. The key takeaway is that the intestinal ecosystem is more suited to yeasts and molds than mushrooms, but advancements in mycology and gut health research may reveal unexpected possibilities. Practical tips for those curious about gut fungi include consuming fermented foods rich in beneficial microorganisms and avoiding excessive antibiotic use, which can disrupt fungal-bacterial balance.
Can Mushrooms Thrive in Cold Climates? Exploring Low-Temperature Growth
You may want to see also

Health Implications: What are the health risks if mushrooms grow in the intestines?
Mushrooms growing in the intestines is an extremely rare phenomenon, often linked to a condition known as intestinal myiasis caused by fungal infections or the ingestion of contaminated food. While the human gut is inhospitable to most fungi due to its acidic environment and resident bacteria, immunocompromised individuals or those with severe gastrointestinal disorders may face heightened risks. For instance, *Candida* overgrowth, though not a mushroom, illustrates how fungi can exploit weakened defenses, leading to systemic infections. Documented cases of intestinal mushrooms are scarce, but they underscore the importance of understanding potential health risks in vulnerable populations.
Analyzing the health implications, the presence of mushrooms in the intestines could lead to mechanical obstruction, nutrient malabsorption, or toxic reactions. Fungal hyphae, if left unchecked, might penetrate intestinal walls, causing perforations or abscesses. Symptoms could mimic gastrointestinal disorders—abdominal pain, bloating, diarrhea, or unexplained weight loss—making diagnosis challenging. In severe cases, fungal toxins released into the bloodstream could trigger sepsis, particularly in those with HIV/AIDS, organ transplants, or prolonged antibiotic use. Early detection through endoscopy or imaging is critical, but misdiagnosis is common due to the condition’s rarity.
From a preventive standpoint, maintaining a robust immune system and practicing food safety are paramount. Avoid consuming wild mushrooms unless properly identified, as some species contain toxins or spores that could germinate under unusual conditions. Probiotics and antifungal medications may be prescribed for at-risk individuals, but overuse can disrupt gut flora, creating opportunities for fungal colonization. For children, the elderly, or those with chronic illnesses, regular medical check-ups can identify predisposing factors like diabetes or inflammatory bowel disease. Hygiene measures, such as washing produce thoroughly, reduce the risk of ingesting fungal spores.
Comparatively, while intestinal mushrooms are rare, they share similarities with conditions like *Aspergillus* or *Mucor* infections in the sinuses or lungs, which also exploit compromised immunity. Unlike these, intestinal cases often require surgical intervention to remove fungal masses, followed by antifungal therapy. The rarity of such cases limits research, but parallels with other fungal infections suggest that prompt treatment is essential to prevent mortality rates exceeding 50% in severe cases. Public awareness and medical education are crucial to recognizing this unusual but life-threatening condition.
In conclusion, while mushrooms growing in the intestines are exceptionally rare, their health implications are severe, particularly for vulnerable individuals. Mechanical complications, systemic infections, and diagnostic challenges highlight the need for vigilance in at-risk populations. Prevention through immune support, food safety, and early medical intervention remains the most effective strategy. As medical science advances, understanding this phenomenon could shed light on broader fungal-host interactions, emphasizing the importance of treating even the rarest conditions with urgency.
Mushrooms in Granola: Unlikely Growth or Culinary Myth Explored
You may want to see also
Explore related products

Prevention Methods: How can one prevent mushrooms from growing in the intestines?
Mushrooms require specific conditions to grow: moisture, organic matter, and a suitable temperature range. The human intestine, while warm and rich in organic material, is not an ideal environment for fungal growth due to its acidity, immune defenses, and lack of oxygen. However, certain factors can disrupt this balance, making prevention crucial for those at risk. Understanding these factors is the first step in safeguarding intestinal health.
Dietary Adjustments: Starving the Fungus
Fungi thrive on sugars and simple carbohydrates, which can promote their growth if consumed excessively. Reducing intake of refined sugars, processed foods, and high-glycemic fruits can deprive potential fungal colonies of their primary energy source. Incorporating antifungal foods like garlic, coconut oil, and oregano oil into your diet may further inhibit fungal proliferation. For individuals with compromised immunity or gut dysbiosis, a low-sugar, high-fiber diet is particularly effective. Probiotic-rich foods such as yogurt, kefir, and fermented vegetables can also restore beneficial gut flora, crowding out opportunistic fungi.
Medications and Supplements: Targeted Interventions
In cases where dietary changes are insufficient, antifungal medications or supplements may be necessary. Prescription drugs like fluconazole or nystatin are commonly used to treat systemic fungal infections, but their use should be guided by a healthcare professional due to potential side effects and dosage requirements (typically 100–200 mg daily for adults). Over-the-counter supplements like caprylic acid or grapefruit seed extract offer milder alternatives, though their efficacy varies. Always consult a doctor before starting any antifungal regimen, especially for children, pregnant women, or those with pre-existing conditions.
Lifestyle Modifications: Creating an Unfavorable Environment
Beyond diet and medication, lifestyle changes play a critical role in prevention. Maintaining proper hydration ensures regular bowel movements, reducing the time fungi have to colonize. Avoiding excessive alcohol consumption is essential, as it weakens the immune system and disrupts gut flora. Regular exercise improves circulation and immune function, further deterring fungal growth. For individuals prone to fungal infections, wearing breathable clothing and managing stress through techniques like meditation or yoga can also support gut health.
Monitoring and Early Intervention: Staying Ahead of the Curve
Regular health check-ups, especially for those with diabetes, HIV, or other immunocompromising conditions, are vital for early detection of gut abnormalities. Symptoms like persistent bloating, unexplained weight loss, or changes in stool consistency warrant immediate medical attention. Stool tests or endoscopic examinations can identify fungal overgrowth before it becomes systemic. Proactive monitoring, combined with the strategies outlined above, provides a robust defense against intestinal fungal growth, ensuring long-term gut health.
Can Mushrooms Grow in Ears? Unraveling the Truth Behind the Myth
You may want to see also

Scientific Evidence: Is there any documented evidence of mushrooms growing in human intestines?
The notion of mushrooms growing in the human intestines is a fascinating yet scientifically dubious concept. To address this, we must first understand the conditions required for fungal growth: moisture, organic matter, and a suitable temperature range. The human gut, while warm and moist, is a highly regulated environment dominated by bacteria, not fungi. Scientific literature overwhelmingly supports the idea that the gut microbiome is primarily bacterial, with fungi comprising less than 0.1% of the total microbial population. This raises the question: is there any documented evidence to challenge this understanding?
Analyzing existing research, no peer-reviewed studies have conclusively demonstrated mushrooms growing in human intestines. Claims often stem from anecdotal reports or misinterpretations of fungal presence in the gut. For instance, *Candida* species, a type of yeast, are commonly found in the gastrointestinal tract but are not mushrooms. Mushrooms, such as those in the *Agaricus* or *Boletus* genera, require specific substrates like soil or wood to grow, which are absent in the intestinal environment. Even in cases of severe gut dysbiosis, fungi detected are typically yeasts or molds, not mushroom mycelium or fruiting bodies.
From a practical standpoint, the idea of mushrooms growing in the intestines lacks biological plausibility. The gut’s pH, enzymatic activity, and immune defenses create a hostile environment for mushroom growth. For example, stomach acid (pH 1.5–3.5) would likely destroy fungal spores before they could establish. Additionally, the rapid transit of food through the digestive system (24–72 hours) leaves insufficient time for mushrooms to develop. Even in immunocompromised individuals, fungal infections like aspergillosis or mucormycosis involve molds, not mushrooms, and are localized rather than systemic.
Comparatively, while fungi like *Saccharomyces boulardii* (a yeast) are used as probiotics, their role is distinct from that of mushrooms. Probiotic yeasts are single-celled organisms that can survive gut conditions, whereas mushrooms are multicellular fungi requiring specific growth conditions. This distinction underscores the importance of scientific rigor in differentiating between fungal presence and mushroom growth. Misinformation on this topic can lead to unfounded fears or misguided treatments, such as excessive antifungal use, which can disrupt the gut microbiome.
In conclusion, scientific evidence does not support the claim that mushrooms can grow in human intestines. While fungi are present in the gut, they are not mushrooms, and their role is vastly different. Understanding this distinction is crucial for both medical professionals and the public to avoid misinformation and focus on evidence-based practices. If concerns about gut health arise, consulting a healthcare provider for proper diagnosis and treatment is always recommended.
Can Mushrooms Thrive in a Terrarium? A Complete Guide
You may want to see also
Frequently asked questions
No, mushrooms cannot grow in the human intestines. The human gut environment lacks the necessary conditions, such as light, oxygen, and specific nutrients, that mushrooms require to grow.
While mushrooms themselves cannot grow in the intestines, certain fungi, like Candida, can naturally exist in the gut microbiome. However, these are not mushrooms but yeast-like fungi.
No, consuming mushrooms does not cause them to grow inside the intestines. Mushrooms are digested and broken down like other foods, and their spores or cells cannot survive or reproduce in the gut environment.
There is no known medical condition where mushrooms grow in the intestines. Fungal infections in the gut, such as candidiasis, involve yeast-like fungi, not mushrooms.